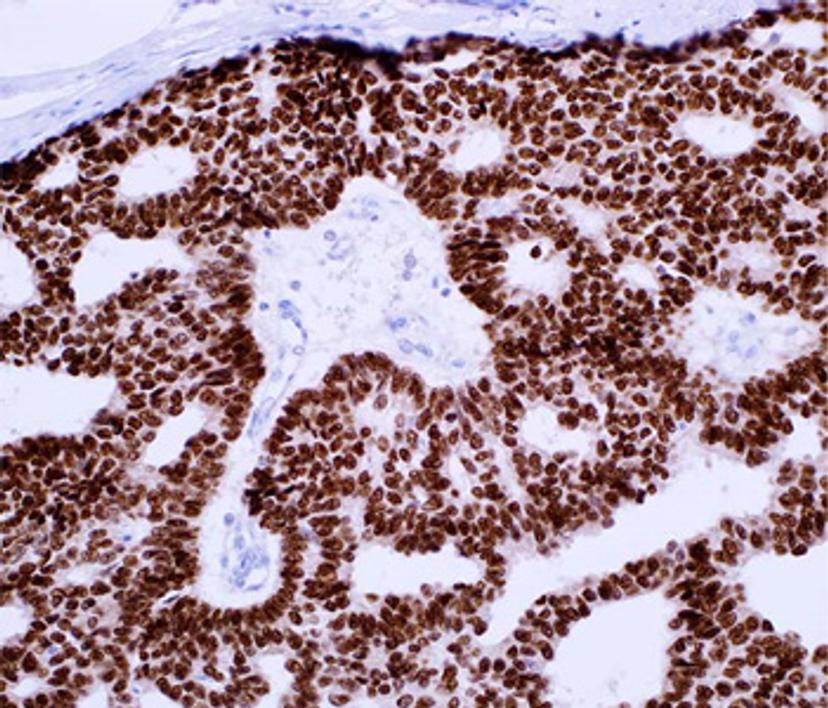

Correlating breast cancer subtypes to clinical outcomes and targeted therapeutics in an era of personalized medicine
Discover how immunohistochemistry is supporting the identification of molecular subtypes of breast cancer
18 Jan 2022
In this SelectScience article, we talk with experts across pathology and cancer diagnosis on the current landscape of immunohistochemistry (IHC) for solving diagnostic problems, and explore some of the main challenges facing the diagnosis of breast pathology today.
The main subtypes of breast cancer based on gene expression1:
- Luminal A (ER+ and/or PR+, HER -, low levels of Ki-67)
- Luminal B (ER+ and/or PR+, HER -/+, high levels of Ki-67)
- Triple-negative or basal-like (ER-, PR-, HER -)
- HER2-enriched (ER-, PR-, HER +)
ER, estrogen receptor; PR, progesterone receptor; HER2, human epidermal growth factor receptor 2; Ki-67, Ki-67 antigen (a cell proliferation marker).
The incidence of breast cancer is rising. It is now the most common type of cancer and, according to the World Health Organization (WHO), now accounts for 12% of all new annual cancer cases globally. Like many cancers, breast cancer is the focus of increasing numbers of research studies, producing more data than ever before in an attempt to help diagnose molecular subtypes and ultimately support a personalized medicine approach. These subtypes demonstrate the molecular diversity of breast cancer, and the correlation of these groups with clinical outcomes and response to targeted therapeutics will be key to moving medicine forward.
Isaac Milos, global product manager at Merck, who has over 14 years’ experience within the tissue diagnostics industry, describes the current landscape of immunohistochemistry for solving diagnostic problems or determining prognosis and response to therapy in breast pathology. “While there are more methods than ever to interrogate patient samples for insights, biomarker analysis through IHC remains a critical methodology to support patient diagnosis or prognosis following tissue biopsy,” shares Milos. “The ubiquitous availability of required IHC equipment, lower cost compared with some other methods, and fast turnaround time all support its continued use – and new generation assays can provide data even at the mutation specific level.”
The ability to evaluate breast cancer biopsies using IHC is indeed seeing a new generation of progress, and while assessing the presence of standard biomarker expression, including ER, PR and HER2 is still critical, this is now complemented by a number of more recently adopted biomarkers to help support differential diagnosis of breast cancer subtypes. “Some of the oldest companion diagnostics are related to breast cancer, with HER2, ER and PR tests based on IHC,” says Jeff Gordon, strategic partner manager with Merck tissue diagnostics. He continues, “Beyond that, in terms of differential diagnostic tests, there have been many markers that have come out over the last 7-8 years, such as p120 Catenin, which now helps to positively differentiate between lobular and ductal carcinomas, and GATA3, which is a key marker to help differentiate breast and non-breast tissue whenever you have metastatic breast carcinomas.”
Dr. Qin Su, pathologist at Merck, tells us more about these markers and their classification; “IHC is a very important part of breast pathology in terms of diagnostic validation and precision diagnostics. For IHC, we use various biomarkers, and these markers can be classified on the diagnostic purposes”. These classifications include:
Differentiation of neoplastic lesions from hypoplastic lesions, including mitotic markers such as Ki-67 and mutation markers like p53
Differentiation between invasive and pre-invasive neoplastic lesions, including myoepithelial cell markers, such as CK5/6, CK5/14, SOX-10, myosin smooth muscle, p63 and p40
Differentiation between ductal carcinoma and lobular carcinoma, such as E-cadherin and p120 Catenin
Subgroup identification, such as hormonal positive groups, triple-negative carcinoma, HER2 positive breast carcinoma that is of diagnostic, prognostic, and therapeutic significance
Identification of breast carcinoma metastasis (and micro-metastasis)
Prognostic markers for the identification of groups with high-risk of distant metastasis or local recurrence.
Merck and the Cell Marque™ Tissue Diagnostics division has a long history and keen focus on IHC and has a wide array of markers that can be used for almost any application when it comes to breast pathology. Not only does this include some of the most widely used therapeutic markers across all labs, such as ER, PR and HER2, but also Class I antibodies. “These [Class I antibodies] are used for subtyping and for differential diagnostics. Cytokeratin 7, Cytokeratin 20, TTF-1 are all used in a differential panel to distinguish things like lung versus breast, or breast versus colon cancers, for example,” explains Gordon.

With a drive to improve the options available to IHC-based analysis, Merck have also been specializing in subtyping breast carcinomas:
- Ductal versus lobular carcinomas – The only antibody that was available for this was E-cadherin. Unfortunately, this antibody has low sensitivity, but the use of p120 Catenin alongside E-cadherin enables pathologists to positively identify lobular carcinomas of the breast.
- Invasive versus noninvasive breast carcinomas – This can be essential for the diagnosis of ductal carcinoma in situ (DCIS), a premalignant condition defined by the proliferation of cancer cells in ductal epithelium. A breach in the myoepithelial layer in this cancer marks DCIS with microinvasion2. While smooth muscle myosin can be used to identify myoepithelial cells, backup markers such as p63 and p40, which Merck now offer, are essential to ensure that these cells are not missed and hence aid in improving the accuracy of diagnosis.
Overcoming the bottlenecks facing histopathology labs
There are a number of challenges facing the diagnosis and effective treatment of breast cancer, ranging from the need for more accurate assays to select for high-risk lesions from lower-risk lesions, to the presence of varied criteria used in diagnosis for some subtypes. While new markers can help support differential diagnosis, with more markers comes the issue of standardization across labs, not only on the use of prognostic markers, but on results interpretation.
There’s also the issue of throughput. Getting cases to a pathologist for review in a timely fashion is a constant challenge for high-throughput histopathology labs, as is adding new markers into existing workflows, keeping sufficient inventory of tests in high demand, and reducing the frequency of lot specific validations.
Some of these challenges have been addressed by Merck. Working directly with labs and other manufacturers that specialize in automation, Merck have been aiming to cut down turnaround times and the extended labor involved in testing. Gordon tells us, “Merck have helped by offering larger panels with more advanced antibodies that are compatible with automated platforms. We [Merck] have also introduced a lot of antibodies that are ready to be used, plug and play-style, onto automation platforms without extended dilution testing.” Brent Heller, who has been working in Merck tissue diagnostics for nearly a decade, adds, “Merck offers large-volume sizes in many antibodies to help streamline workflows. That same thought continues with same batch shipments, allowing for fewer lot to lot verification events. We aim to minimize extraneous testing and keep the focus on patient care.”
The takeaway from Heller is clear. “While IHC may appear to be an aging, almost commoditized test, with the development of new antibodies, labs are now supported to make a more specific diagnosis for patients.” Antibodies developed recently allow for the identification of a combination of markers, enabling more specific subclassification of tumors. This benefit is achieved with additional tests, not new tests, all with diminishing specimen size, inventory management and cuts in reimbursement. Heller concludes: “We are constantly evaluating novel antibodies to bring to market and increase the diagnostic tool belt of the pathologist, ultimately, seeking to change the narrative from You have this cancer, to this is Your cancer.”
References
Fragomeni SM, Sciallis A, Jeruss JS. (2018) Molecular Subtypes and Local-Regional Control of Breast Cancer. Surg Oncol Clin N Am. 27(1):95-120
Firdous S, Anjaneyulu, Fonseca D, Murthy S, Challa S, et al. (2018) The Study of Ductal Carcinoma In Situ (DCIS) with Microinvasion Using Myoepithelial Markers. Int J Pathol Clin Res. 4:074